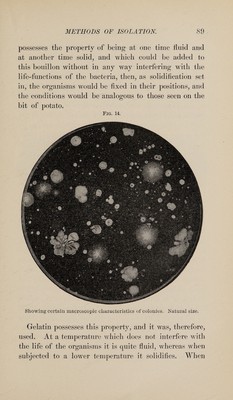

The principles of bacteriology : a practical manual for students and physicians / by A.C. Abbott.
- Abbott, A. C. (Alexander Creever), 1860-1935.
- Date:
- [1902]
Licence: Public Domain Mark
Credit: The principles of bacteriology : a practical manual for students and physicians / by A.C. Abbott. Source: Wellcome Collection.
1/662